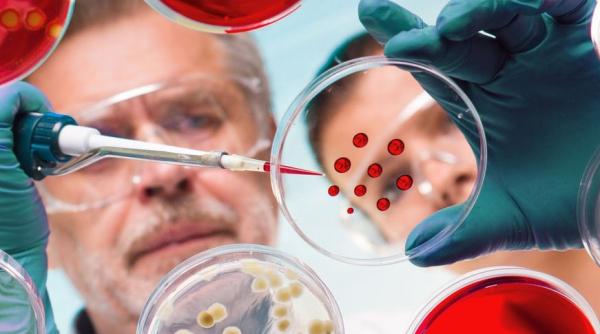
Americanii avertizează. Începe o epidemie globală de superinfecții

Furtună în PSD. Viorica Dăncilă a demisionat de la șefia partidului
Preşedintele PSD, Viorica Dăncilă, a demisionat din funcţie, în locul său fiind numit preşedinte interimar Marcel Ciolacu, a anunţat liderul PSD Sector 1, Dan Tudorache, la finalul şedinţei...
27 Noiembrie 2019